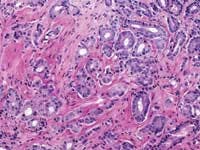

Executive Forecast
Interview by Carren Bersch, Editor
The American Cancer Society estimates that 220,900 men were diagnosed with prostate cancer last year in the United States, with 28,900 deaths attributable to the disease. When the prostate biopsy test results for one of our co-workers came back with a positive result for cancer in 2002, we learned that statistics, however shocking, are fairly impersonal until one of those 220,900 is an acquaintance, a friend, a relative, or a business associate.
In 2001, our co-worker tested negative for prostate cancer. A year later, the same test was performed and four of his 11 samples were cancerous. In both years, the specimens were sent to a lab owned by the urology team that did the biopsy. Subsequent tests on the 2002 samples by two other laboratories showed that the cancer was present, yet these laboratories had different results than the first. One of the outside labs indicated that the cancer was more aggressive (a Gleason 8 score) than the other labs that showed a maximum Gleason score of 7. The Gleason 8 score required more radiation and two years of medication, whereas a Gleason 7 had it been the accurate test would have required less radiation and only three months of medication.
Sensitivity and specificity
John E. Tomaszewski, MD: In reference to the submitted case, three related but separate issues with respect to problems in laboratory testing for prostate cancer are illustrated. The first issue has to do with the localization of prostate cancer within a gland. The second is the microanatomic recognition of carcinoma in tissue section. The third is the use and development of prognostic markers in prostate cancer.
Pre- and post-analytic variance
Tomaszewski: The standard PSA test is an automated assay with little in the way of analytic variance. While it is always possible for an individual lab technician to make an error in the operation of the analyzer, the standard management of clinical laboratories makes that very unlikely. A much more significant problem is with pre-analytic variance. This refers to all the problems, which can happen before the test even gets to the machine. For example, if the specimen is mislabeled or poorly handled, a value may be in error. Clinicians need to take more responsibility in assuring the lab that the materials (blood, urine, tissue) they submit for testing are properly labeled, handled, and transported. Point-of-care testing is coming, which will move instrumentation to clinicians offices and likely introduce more variance in the analytic component of the testing cycle, since nonlaboratory professionals will operate this instrumentation. This is a patient-safety issue that should be watched very carefully in the future.
If a lab test is modified, it becomes a new test; this new test has a new reference range and new operating characteristics. This means that the sensitivity, specificity of the test in relation to the disease prevalence of interest has to be re-evaluated for the new test. Labs are responsible for publishing the appropriate new reference ranges. The clinicians are responsible for integrating these reference ranges into their recognition of the value of the test for a particular patient. For example, age and race stratification are critical pieces of information that factor into the interpretation of a PSA value. Prostate size and interval changes are other important features. These factors can only be meaningfully integrated into some decision analysis by the clinician. Unfortunately, many primary care clinicians are much uninformed regarding these matters. This variability of interpretive acumen is termed post-analytic variance. The most effective improvements in PSA testing can be made in addressing the places where there is the most variance (i.e. the pre- and post-analytic areas).
Grade 1: (Not pictured) Simple round glands of uniform sizes, closely packed in rounded masses with well-defined edges.Zarbo: As a generalization, the variation in PSA test results due to biologic factors far outweighs that of methodologic testing variation from different platforms which, in turn, far outweighs any technical test variation. The odds that a lab test result will be skewed because of a lab technician are extremely rare, as barcode-labeled blood tubes are routinely loaded onto automated chemistry test platforms for analysis with the usual attention to test quality control and quality assurance. I would venture that a med tech following usual laboratory protocols would have little to do with any possible test variation.
There is test variation across all platform-testing methods for PSA, with tighter variation within test methods and platforms. For that reason, it is best to have ones PSA done by the same lab for longitudinal tracking. Even within the normal range of PSA values, the CAPs proficiency-testing surveys have shown a mean CV of 7% with range from 16% at the upper limit (4ng/mL) to greater CVs of up to 35% at extremely low PSA levels of 0.1-0.2 ng/mL. Given these provisos, comparable results may be expected anywhere, as the same automated test platforms may be found in any laboratory setting be it a large teaching hospital, small community hospital, or large commercial laboratory.
Room for improvement?
Tomaszewski: Clinical labs already function under a rigorous set of standards. Assays are FDA approved through a prolonged process. Lab performance is monitored by both state and federal oversight through either direct inspection or inspection by organizations with deemed status. So, standards for clinical labs are in place. Making all inspections unannounced could enhance continuous compliance. All personnel responsible for clinical lab testing should be certified medical technologists. Professional standards for diagnostic pathologists are administered by the American Board of Pathology, which has yet to establish a subspecialty board in surgical pathology. This should be done. All pathologists responsible for histopathological diagnosis should have this certification, in addition to primary boards.
For lab technicians, I like to see compulsion in the cross checking of detail. This fly-by-the-numbers approach is the best protection against error. More importantly, however, is the system in which the lab tech must work. Lab factories, which put production in front of safety, should be penalized. Work standards putting caps on maximal allowable activity per unit time are important for both lab technicians and surgical pathologists. These sorts of standards currently do not exist. The development of lab information systems has not kept pace with need. As reimbursement margins have shrunk, it is simply not very profitable for companies to develop new and safer information systems. The reimbursement profiles in lab tests should be readjusted to reflect the need for continuous capital investment as a component of patient safety.
Screening techniques and biopsy procedures
Tomaszewski: Our current screening methods rely heavily on PSA testing to identify a population at increased risk. After this initial testing, the identification of prostate cancer is dependent on a blind approach to gland sampling. Since each needle biopsy sample is less than 1/100,000 of the gland tissue, the possibility for false-negative results is significant. Therefore, in my opinion, one of the critical issues in the diagnosis of prostate cancer is to develop directed biopsy techniques, which will enrich the chances of successfully sampling prostate cancer when it is truly present. Ultrasound as a localization technique has not been successful to date. We have been interested in high resolution MRI as a localization technique. Biomarker imaging may be another way to identify hot spots which are at risk. It is likely that some combination of a better serum or urine screening test (some super PSA type marker) linked to an effective imaging technique will be a better way of finding the tissue loci which harbor the prostate cancer.
The techniques of DRE, TRUS, and PSA do not diagnose prostate cancer. They only establish an increased likelihood that prostate cancer may be present. The only way to make a diagnosis of prostate cancer in 2004 is to do a biopsy. A negative biopsy does not exclude the possibility of cancer somewhere else in the unsampled gland. In the absence of a definitive carcinoma in the biopsy, there are certain features, which raise the index of suspicion. These features are the finding of (1) high-grade prostatic intraepithelial neoplasia, or (2) atypical small acinar proliferations. Other possible but as of now not well defined features of concern are atypical adenomatous hyperplasia, post-atrophic hyperplasia, and proliferative inflammatory atrophy.
Zarbo: For all of the reasons that impart lack of specificity, PSA test results need to be interpreted by a urologist in the context of the clinical symptoms, and in conjunction with a digital rectal exam and then if warranted possibly a transrectal ultrasound examination. Should the work-up progress to needle biopsies of the gland, another set of factors can be encountered that may impart variability to the biopsy interpretation, which is the scenario initially painted here.
Gleason grading system; gene discovery
Zarbo: The issue of variation in pathologist interpretation of histologic biopsy secondary characteristics such as Gleason grade is well known. There exists the possibility of interobservor variation (e.g., between pathologists), as well as intraobservor (same pathologist) variation. Much of this variation can be diminished by standardization through education and training. For instance, the Johns Hopkins Pathology website provides a Gleason grading tutorial that may be helpful in illustrating images of critical grades, like grade 4, that may influence therapeutic decisions.
Tomaszewski: The Gleason grading system is the most powerful grading tool for the prediction of outcome amongst all the tumor systems. In almost every study ever performed, the Gleason grading system has statistically proven independent predictive value. Since, however, the Gleason grading system is a complex 10-level system, concordance levels in its application are only moderately good. The most critical threshold in the Gleason system is in the recognition of patterns 4 and 5. Once again, enhanced continuing medical education (CME) for pathologists is the most immediate remedy for improving the efficiency of patterns 4 and 5 recognition, and computer-assisted diagnosis (CAD) techniques could, in the future, facilitate this recognition. The public, however, must understand that even in the best of circumstances, the predictive power of the Gleason test is limited.
Continuing medical education
Tomaszewski: While many clinicians and most patients see the diagnosis of cancer as Yes, I have it or No, I do not have it, the reality of diagnostic certainty is not that simple. Currently, the diagnosis of prostate cancer can only be made by histopathological recognition. In essence, a diagnosis of prostate cancer is a probability statement based on morphology. The statement is that given a certain image pattern, there is a significant chance that the patient under examination will have disease progression, which will cause him morbidity or death. In 2004, this is first an issue of improving CME for pathologists. There are many false-positive and false-negative mimics. The role for more effective CME is to help pathologists assure their accuracy and effectiveness in diagnosis. Better training systems will help assure the reproducible separation of false positive from true positive and false negative from true negative. The case given in illustration highlights an apparent false-negative result.
The CME training for the pathologist handling that case should focus on the search and recognition functions for identifying prostate cancer. Some of this enhanced training will take the form of more pervasive and effective delivery of traditional CME. Other novel approaches to image-based diagnosis will appear in the next 10 years. CAD, once again, may play a role in the future. In CAD, image science combines with large image databases of ground truth to facilitate the recognition and confirmation functions of morphology-based diagnosis. Finally, molecular testing has always been dreamed of as assuming a primary role in the definitive diagnosis of prostate cancer. This is another goal whose science will need substantial time to evolve.
The molecular revolution will most likely be most successful in identifying biological markers, which predict responsiveness to particular therapies. The most interesting development in the past three years comes out of the gene discovery arena. This activity has focused on 30+ genes, which change their expression levels in prostate cancer. While many of these were known players, this activity has pulled together a panel of gene targets, which may represent pathways that may be amenable to therapeutic targeting.
John E. Tomaszewski, MD, is director of surgical pathology, professor of pathology and laboratory medicine at the Hospital of the University of Pennsylvania, and Richard J. Zarbo, MD, DMD, serves as chair for the department of pathology at Henry Ford Hospital and Medical Group, and as senior vice president for pathology and laboratory medicine at the Henry Ford Health System.
February 2004: Vol. 36, No. 2